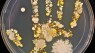
Mom Grows Son's Hand Bacteria In Sterile Plate ... Yuck

Keepsakes to remember your children when they were little are pretty common and super cute.
You know, things like handprint ornaments and footprint plaques.
Well, here's a new one: What about putting your son's hand in some sterile plates and growing his bacteria in it? 'Cause that's what you're looking at.
Tasha Sturm, who works at Cabrillo College, decided she'll remember her son's germs —always.
She said in her American Society for Microbiology post she used sterile plates and tryptic soy agar, or TSA, which is a substance used to cultivate bacteria to get the print.
She said in the comments she cooled the TSA to about 55 degrees and poured it into a plate. She covered it to let it solidify and then pressed her son's hands into the agar. She then put it in an incubator for a day or two, set it out at room temperature for a few days and voila: bacteria.
She did caution that once the plate is finished, it should be treated as a biohazard and "disposed of properly."
But don't panic about all that bacteria because it's not all bad. According to The Colossal, "It's safe to say almost everything you see growing in this specimen is harmless and in many cases even beneficial to a person's immunity."
But still, hand washing is a very, very good thing.
And it's true, some bacteria is good for you, like uses in medicine to bolster our immune systems. The Alimentary Pharmabiotic Centre explains we couldn't live without some bacteria.
And Sturm confirmed via email the bacteria we see was normal and "how we build a healthy immune system."
But still, it's kinda creepy to look at and realize all these bacteria are on our hands.
This video includes images from Kansas City Photography, kellypuffs / CC BY 2.0 and Selbe <3 / CC BY NC ND 2.0.